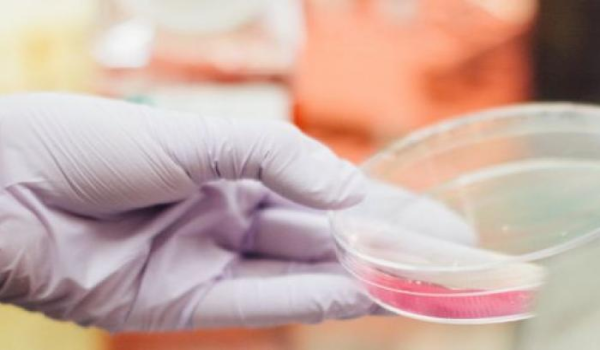

عثر باحثان في عام 2011 في دراستين مستقلتين على نتائج مهمة وغامضة، إذ وجد الدكتور ماثيو مايرسون من معهد دانا-فاربر للسرطان والدكتور روبرت أي هولت من جامعة سيمون فريزر في كولومبيا البريطانية جراثيم تعيش عادة في الفم وتُدعى البكتيريا المغزلية تستوطن خلايا سرطان القولون البشرية.
وفي دراسة حديثة نُشِرت في مجلة العلوم، أكَّد مايرسون وزملاؤه وجود جراثيم البكتيريا المغزلية في خلايا سرطان القولون لدى نصف المصابين به، ودرس الباحثون على وجه الخصوص أورام القولون البشرية التي تنتشر إلى الكبد، ووجدوا أن الانتشارات بقيت تحمل البكتيريا المغزلية حتى بعد انتقالها إلى الكبد.
في المقابل، لا تتضمن الخلايا الورمية التي نشأت من الكبد أصلًا على هذه الجراثيم، ولمزيد من التوضيح، حقن فريق مايرسون خلايا السرطان البشرية في أربعة أجيال من الفئران، فكانت جراثيم البكتيريا المغزلية تستوطن الخلايا الورمية في كلّ جيل.
وقد حيَّرت هذه النتائج العلماء، وقال مايرسون لنيويورك تايمز «إنَّ التفسير الأفضل لهذه النتائج أن انتشارات السرطان التي تهاجر إلى الكبد تحمل معها هذه الجراثيم، لا يمكن أن تقترن هذه الجراثيم مع الخلايا الورمية بالصدفة، لذا فإننا نظن أنها جزء أساسي من السرطان».